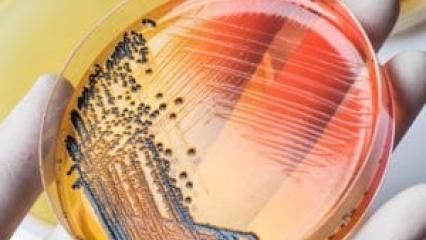

Catalogue
Nous nous engageons à répondre à vos demandes d'inscription sous 15 jours.
-
-
Parcours d'insertion 2
-
-
3
-
Sécurité de la personne 22
-
Incendie 6
-
Risques électriques 20
-
Risques liés aux travaux spécifiques 12
Il s'agit de la prévention des risques relatifs à divers types de travaux (enfouissement, destruction....) -
Travaux en hauteur 7
-
Manutention, transport et conduite en sécurité 4
-
Risques chimiques 3
-
-
5
-
La relation dans la prise en charge, l'accompagnement et le soin 26
-
Amélioration des pratiques professionnelles 25
-
Formations à destination des travailleurs en ESAT 10
-
Les règles d'hygiène fondamentales 11
-
-
-
Communication 12
-
Management 10
-
Développement Personnel 4
-
-
1
-
Bureautique 26
-
Conception et dessin assisté par ordinateur - CAO - DAO 3
-
Communication digitale 3
-
-
10
-
5
-
5
-
7
-
3
-
1